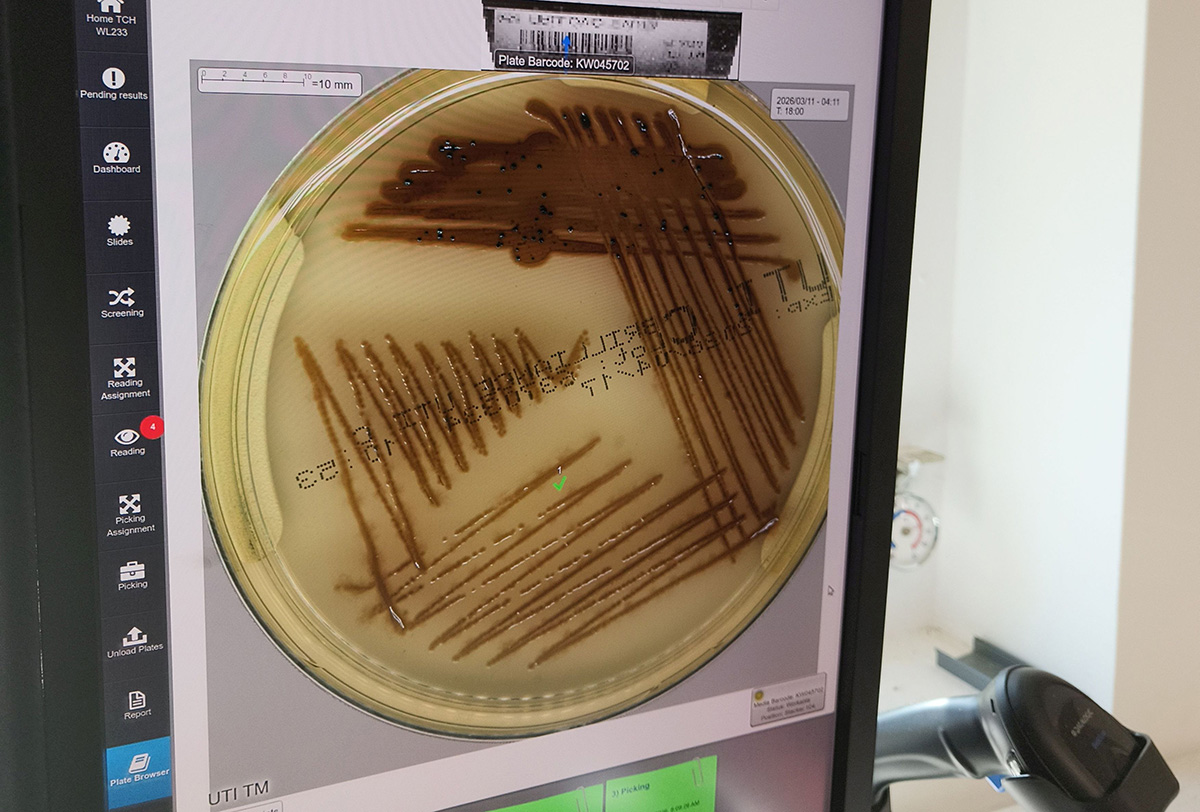

Femeia din fața mea e tânără nu doar pentru că viața i-a permis norocul (la care a migălit, de altfel, și ea cu minuțiozitate) să își cultive propria grădină, ci pentru că poate să o și împartă.
Cred că face parte dintre acei puțini oameni pe care îi întreabă foștii colegi, la câte o întâlnire dintre acelea, cu ani rotunzi de la terminatul școlii, de ce ea nu îmbătrânește.
Și o văd trebăluind la lucruri ce, de ai schimba doar mărimea, ar fi jungle ecuatoriale, și lacuri, și întâmplări de capă și spadă cu animale nemaivăzute, bune de desene animate puțin SF-icești. Și o invidiez. Cu o invidie de aia bună, că, uite, ce fain e ceea ce faci, sau că, de ar fi să aleg iar începutul de drum, mi-ar plăcea să o iau pe calea pe care ai luat-o tu, și să stau în uruitul tehnic ce leagănă pădurile în miniatură, să crească.
Pentru că doamna dr. Daliborca Vlad este profesor universitar, și șef al laboratorului ce ține pe picioare cel mai mare spital din vestul țării, Spitalul Clinic Județean de Urgență „Pius Brînzeu” Timișoara. Și ce spital e acela care poate să ființeze fără să aibă un laborator care merge ceas? Și ce spital e acela care nu ar recunoaște și aplauda munca celor care nu țin pacientul de mână, dar ajută enorm și intrinsec ca starea lui să fie înțeleasă și îmbunătățită?
Recunosc o vină. Sunt printre cei îndrăgostiți de munca de laborator. Vină pentru că, atunci când scrii, ca jurnalist, despre medicină, nu e întrutotul fain să ai un „pole position”. Dar… să lăsăm ipocrizia. Toți venim de undeva, toți avem dorințele noastre, experiențele noastre, în spate, poate și temerile, poate și realizările, prieteșugurile, încercările și reușitele în a înțelege.
Pe atunci când se sortau lucrurile în jur, și trebuia să mă decid dacă merg pe drumul pe care voia a apuca grosul clasei mele de liceu, adică medicina, eu am ales altceva. Am devenit chibiț de medicină, un fel de punte de înțelegere între ce se întâmplă acolo, în spitale, și cabinete, și săli de operație, și eprubete de laborator, și cei care suferă, sau au pe cineva ce are nevoie de un leac, sau doar (deși nu e deloc ceva ce micește – dimpotrivă) vor să înțeleagă. Dar asta nu înseamnă că am uitat ce făceam atunci, la început, cum prima mea diplomă e cea de laborant biochimist.
Oh, zilele cu halatele noastre improvizate, de toate felurile și de toate proveniențele, și felul în care ne strecuram, încercând să nu încurcăm, prin laboratorul doamnei Dărăban, la Municipalul din Arad, unde mi-am scris nu-mai-știu ce lucrare de final, din reacția de floculare folosită pentru diagnosticarea sifilisului…
Nu cred că e așa de ușor de înțeles din afară – voi, mamele voastre, bunicile sau nevestele strâng bibelouri sau bijuterii – noi întorceam capul după eprubete micuțe, subțiri, elegante, după vase Petri, după pahare Berzelius în miniatură, ca pentru păpuși, și ni le doream. Chiar povesteam cu cei pe care i-am întâlnit în drumul acesta pentru cunoașterea laboratorului de la Județean de încercarea mea de a cultiva plăntuțe noi de Leontopodium alpinum (da, uneori ne vin denumirile latinești în minte înaintea celor laice – asta, de exemplu, e a florii de colț) pe un amestec de agar-agar pe care l-am pregătit acasă… Nu mai spun aici cum am ajuns la meristemele de plantă…
Și le-am mai spus despre un Crăciun în care am folosit, pe post de brad de urare, cele puse într-un Petri să arate exact așa, sărbătoresc. Chiar caut poza pe net, o s-o folosesc și acum, aici, citând sursa: https://www.jcvi.org/blog/holiday-art.
Laboratorul are frumusețea lui aparte, și eleganța lui, și fiecare vas în care „crește ceva”, însămânțat cu presupusele rele ale pacientului, e o pădure în miniatură, pe care trebuie să știi să o mânuiești cu finețe, și să o înțelegi. Cred că toți cei pe care îi vizitezi, ca jurnalist, sunt încântați de văd că te preocupă munca lor, poate chiar mai mult dacă arăți că și înțelegi ceva, încă de dinainte să ți se fi explicat. Dar aici nici măcar nu trebuie să-mi mimez entuziasmul – de fapt e invers, și atunci când ajung lângă locul în care se strâng vasele cu respectivele culturi deja înțelese și catalogate, adică gunoiul, de ar fi să o spunem simplu, doar că aici e totul cu ștaif, respectând norme și obligațiuni, de-abia mă rup de acolo doamnele de la respectivul laborator, și o fac aproape trăgând de mine, pentru că interesul nu e doar interes, e fascinație, și taaaare aș mai răscoli în gunoiul acela, să văd frumusețile și ciudățeniile fiecărui vas în care… a crescut ceva.
Dar mi se arată, nu de-a valma, ci cu răbdare, la microscop, ce a crescut, și pozez, și apoi vorbim despre cele mai aparte ce au fost găsite acolo, gen Candida auris, forte contagioasă – dar aici totul e gândit, contabilizat, pus în găoace de sticlă și plastic și ținut ferit, să poată fi prețăluit fără a face rău. Urmăresc eprubetele, în drumul lor mecanizat, ascult uruitul agregatelor, trecem, în calea noastră, ce implică mai multe etaje și multe cotloane ce nici nu știam că există, în Județean, pe la oameni ce lucrează cu bacterii, cu viruși, cu tot ce e janghină mică și te poate omorî sau da peste cap, mi se spune de toate felurile de analize, din toate felurile de probe, chiar și de o carte faină pe care au scos-o timișorenii pe marginea analizelor de urină, ajungem și la toxicologie, vorbim despre screening și confirmări de droguri, ridic o problemă cu o intoxicație cu tisă a cuiva care a vrut să se sinucidă, prezentată de anestezistul Iuliu Torje de curând, gândim, mi se explică variante – parcă suntem în partea aseptică a unui film cu detectivi.
Întâlnim, în drumul nostru ce pare să nu se termine, pe tărâmul muncii de laborator, mai multe persoane ce îmi explică ce fac sculele lor, și la ce ajută tot (cel mai mult vorbim cu prof. univ. dr. Monica Licker de la Compartimentul Microbiologie, cu chimistul principal Adinela Cimporescu de la Compartimentul Toxicologie, cu prof. univ. dr. Roxana Popescu de la Compartimentul de Genetică și Biologie Celulară și Moleculară și cu dr. Aurora Ștefu de la Compartimentul Biochimie-Imunologie, Linia Automată) și, la sfârșitul drumului, când orele sunt cu mult mai mult decât credeam că vor fi, iar cunoștințele noi deja își cer sertarele, să fie așezate, e timpul și pentru discuția în sine, pe marginea a ce e de văzut aici, la marele laborator, și a măcar puțin din cine e cea care îl conduce.
*
– Cum este structurată munca laboratorului – câți oameni, pe câte ture, care sunt regulile locului?
– Bazele Laboratorului Central de Analize Medicale al Spitalului Clinic Judeţean de Urgenţă “Pius Brînzeu” Timişoara au fost puse odată cu înfiinţarea acestuia în anul 1974, funcţionând ca centru de diagnostic paraclinic, dar şi ca bază de învăţământ universitar şi postuniversitar.
Laboratorul Spitalului Clinic Judeţean de Urgență Timişoara a fost primul laborator public din România acreditat RENAR în 2010, sub coordonarea Prof. univ. dr. Victor Dumitraşcu.
Calitatea activităţii specifice şi performaţele laboratorului sunt menţinute şi permanent verificate ca urmare a participării la programe externe de evaluare a calităţii, atât naţionale cât şi internaţionale în urma cărora laboratorul a primit numeroase certificate.
Activitatea laboratorului este structurată în două ture și linie de gardă. Laboratorul efectuează analize în regim cu prioritate urgență (pacienți care se prezintă în UPU și pacienți internați care prezintă urgențe medico-chirurgicale) și în regim ambulator, respectiv spitalizare de zi și spitalizare continuă.
Colectivul Laboratorului Central de Analize Medicale este format dintr-o echipă complexă de specialiști, după cum urmează: 24 de medici (21 medici primari medicină de laborator, 1 medic primar genetică medicală, 2 medici specialiști medicină de laborator), 5 chimiști principali, 1 biochimist principal, 3 biologi principali, 1 biolog specialist, 1 chimist, 11 asistenți laborator clinic licențiați cu grad principal, 1 asistent laborator clinic licențiat, 14 asistenți laborator clinic cu grad principal, 3 tehnicieni laborator grad principal cu studii superioare de scurtă durată, 2 asistenți laborator cu studii postliceale, 5 asistenți medicali generaliști cu studii postliceale, 6 registratori medicali, 7 îngrijitori curățenie.
Întregul colectiv depune eforturi susţinute pentru modernizarea metodologiei de lucru, prin introducerea de aparatură şi tehnici noi care în ultimii ani a aliniat activitatea laboratorului la nivelul standardelor europene.
– Ce deservește laboratorul și cum se face asta, cum Județeanul nu are toate secțiile în aceeași clădire?
– În prezent, după 50 de ani de existenţă şi activitate neîntreruptă a Laboratorului Clinic de Analize Medicale al Spitalului Clinic Judeţean de Urgenţă „Pius Brînzeu„ Timişoara, acesta este în continuare cel mai mare şi performant laborator din vestul ţării şi datorită calităţii, prestaţiei oferite de personalul acestuia este intens solicitat atât de secţiile clinice ale spitalului cât şi de spitalele din zona de vest a ţării pentru analize sau confirmarea unor rezultate.
În laborator se fac peste trei milioane de determinări anual. De asemenea, prin ambulator pot beneficia de serviciile acestuia şi pacienţii care doresc să-şi efectueze analizele de laborator cu bilet de trimitere de la medicii de familie sau contra cost. Laboratorul aduce, an de an, venituri tot mai substanţiale spitalului atât prin onorarea cererilor din exterior ale pacienţilor, pe bază de bilet de trimitere şi/sau prin activitatea desfăşurată contra cost, prin intermediul policlinicii, cât şi prin onorarea cererilor în urma internărilor de zi.
Deosebit de important este faptul că o mare parte din investigaţiile efectuate atât de către Laboratorul Clinic de Analize Medicale al Spitalului Clinic Judeţean de Urgenţă “Pius Brînzeu” Timişoara, cât şi de alte spitale din Timiş, sunt incluse în pachetul de servicii suportat de la bugetul de stat, şi ca urmare sunt gratuite; cele care nu sunt incluse în acest pachet, sunt la jumătate din preţurile care există în sistemul privat, şi au fost gândite în acest mod tocmai pentru a veni în sprijinul bolnavilor, pentru ca aceştia să beneficieze de investigaţii de calitate şi precizie la preţuri foarte mici.
Întreaga activitate din cadrul Laboratorului Clinic al SCJUPBT se desfăşoară şi în prezent în baza unor protocoale şi proceduri de lucru, conforme cu standardele actuale şi legislaţia în vigoare. Laboratorul Clinic de Analize Medicale deservește toate secțiile clinice, compartimentele, blocurile operatorii, ambulatoriul integrat și nu în ultimul rând activitatea de cercetare.
Pe lângă activitatea medicală paraclinică şi de cercetare ştiinţifică, în Laboratorul Clinic Central de Analize Medicale se desfăşoară şi procesul de învăţământ superior şi postuniversitar, aici pregătindu-se în continuare generaţii întregi de medici.
– Cum stați cu dotările? Ce ar fi util să mai vină?
– Dotarea laboratorului a fost întotdeauna o prioritate deoarece s-a dorit diversificarea şi eficientizarea serviciilor medicale acordate pacienţilor, la cele mai înalte standarde de performanţă, întrucât laboratorul nostru este şi trebuie să rămână unul dintre cele mai performante laboratoare din zona de vest a ţării. Echipamentele de laborator performante contribuie la scăderea semnificativă a timpului de eliberare a rezultatelor şi oferă indicii valoroase cu privire la diagnostic şi monitorizarea terapiei.
Reabilitarea laboratorului a început în anul 1999, fiecare compartiment beneficiind de dotări cu echipamente automate de ultimă generație și înaltă performanță care să poată efectua toată gama de investigaţii solicitate de clinicieni, precum şi de programele de cercetare. Nivelul de pregătire şi calitatea activităţii desfăşurată de personalul angajat al acestuia, a condus la desemnarea Laboratorului Clinic al spitalului ca Laborator Zonal de Referinţă pentru partea de vest a ţării, respectiv Centru Zonal de Referinţă pentru laboratoarele medicale, prin ordinul MS si CNASS nr. 640/167/22.09.1999.
În perioada 2009-2010 a luat naștere în cadrul laboratorului, Compartimentul de Toxicologie, compartiment unic pe partea de vest a ţării la vremea respectivă. Dotarea compartimentului de Toxicologie permite efectuarea de analize toxicologice avansate și servicii de monitorizare terapeutică a medicamentelor (TDM), utilizând tehnologii analitice de ultimă generație pentru determinarea precisă a substanțelor toxice și a concentrațiilor plasmatice medicamentoase. Prin metode validate internațional, laboratorul contribuie la diagnosticul toxicologic de înaltă acuratețe, optimizarea terapiei individualizate și creștere a siguranței pacientului, oferind suport obiectiv pentru decizia clinica și protejarea sănătății publice.
În perioada 2012-2014 a fost iniţiat şi finalizat Compartimentul de Biochimie-Imunologie al laboratorului, care a fost dotat cu o Linie complet automată de prelucrare preanalitică, analitică şi postanalitică a probelor biologice. Achiziţionarea acestei linii de către Ministerul Sănătăţii, linie unică de acest tip în România la momentul respectiv a adus beneficii uriașe.
Începând cu anul 2016, capacitatea de diagnostic a laboratorului a cunoscut o creștere continuă.
Din 2019, pacienţii beneficiază de un secvenţiator şi echipamente conexe pentru detectarea şi cuantificarea agenţilor patogeni, a biomarkerilor de diagnostic şi orientare terapeutică, în special pentru patologia neoplazică, precum şi predispoziţia genetică la anumite patologii. Platforma de secvențiere de nouă generație permite analiza simultană a multiple regiuni genomice prin paneluri țintite, exom sau alte abordări de tip high-throughput. Fluxul bioinformatic include aliniere la genomul de referință, variant calling (SNV, indel), filtrare și anotare utilizând baze de date validate internațional. Această infrastructură susține identificarea variantelor patogene, probabil patogene sau de semnificație incertă, în concordanță cu ghidurile de clasificare recunoscute în practica geneticii clinice.
Având în vedere contextul epidemiologic creat de infecţia cu coronavirus (COVID-19), în anul 2020 laboratorul s-a dezvoltat prin înfiinţarea unui compartiment de Biologie moleculară, care a fost dotat cu toată infrastructura necesară diagnosticului medical bazat pe analiza acizilor nucleici, performanțe necesare testării Coronavirusului.
În 2022 a avut loc înlocuirea primei Linii automate de biochimie umedă şi imunologie din Compartimentul Biochimie – Imunologie, care a funcţionat fără întrerupere între 2014-2022.
De asemenea, pe lângă aceasta, s-a achiziţionat şi o Linie automată de biochimie uscată şi imunodiagnostic ce permite efectuarea determinărilor de biochimie uscată, de imunologie şi imunodiagnostic în cadrul aceleiaşi serii analitice, din aceeaşi probă, având o capacitate de 3,000 teste pe oră de biochimie şi 200 teste pe oră de imunodiagnostic, în regim de 24h/24 şi 7 zile/7. Meniul de teste pentru acest sistem este foarte mare, acoperind o gamă foarte variată de determinări, iar tehnologia de testare este biochimia uscată, ceea ce presupune volum minim de probă şi timp de obţinere a rezultatelor foarte scurt. Tehnologia de biochimie uscată elimină total deşeurile lichide, nu necesită conectare la sistemul de apă şi nici nu există nevoia conectării la sistemul de canalizare.
Pentru a putea răspunde nevoilor, precum şi pentru desfăşurarea activităţii la cele mai înalte standarde de calitate, începând cu anul 2020, laboratorul beneficiază de sistemul de identificare microbiană prin spectrometrie de masă MALDI-TOF, care permite identificarea rapidă a germenilor microbieni din cultură), echipamentul UNYVERO, cu posibilitatea de a se identifica concomitent germeni microbieni și gene de rezistență direct din produsele biologice, într-un interval de timp de 5-6 ore, linie de procesare automată a probelor biologice (WASP) care permite testarea automată a culturilor microbiene standardizate cu creșterea performanței izolării microbiene și o identificare mai rapidă a microorganismelor. În anul 2023 laboratorul a beneficiat de achiziția prin PNRR a unor noi module ale echipamentului WASP, respectiv, linia automată de transport și incubare a probelor (WASP-LAB), beneficiile aduse fiind: scurtarea timpului de diagnostic, scăderea duratei de spitalizare prin abordarea unei conduite terapeutice optime în cel mai scurt timp, ceea ce duce și la scăderea costurilor asociate, rezultate de o performanță și eficiență înaltă, îmbunătățirea condițiilor de biosecuritate, scăderea riscului de expunere la personalul medical, precum și a riscului de afectare a integrității probei.
Din 2023 compartimentul de Genetică și Biologie moleculară dispune de un microscop digital de ultimă generație pentru analiză citogenetică, echipat cu sistem de captură și software dedicat pentru analiza cariotipului fetal (din lichid amniotic sau vilozități coriale) și constituțional. Se realizează analiza cromozomială în bandare specifică (ex. G-banding), cu identificarea anomaliilor numerice și structurale (translocații, deleții, duplicații, inversii), la un nivel de rezoluție adecvat standardelor citogeneticii clinice.
În anul 2025 compartimentul de Genetică și Biologie moleculară a fost dotat cu două analizoare automate de înaltă performanță COBAS 6800 – Roche, care ne-au ajutat pe perioada acestui an să intrăm ca și instituție în programul de screening HPV alături de alte 7-8 instituții din toată țara. În viitorul foarte apropiat aceste analizoare automate ne vor ajuta și în realizarea altor analize: ADN viral hepatita B (cantitativ), ARN viral hepatita C (cantitativ), ADN viral HIV-1 & HIV-2 (calitativ) & ADN viral HIV1 (cantitativ). Deopotrivă compartimentul dispune și de o linie de extracție ADN/ARN și RT-PCR pentru analize precum: HPV-tipaj viral 28 de tulpini, ADN viral hepatita B (cantitativ), ARN viral hepatita C (cantitativ), detecție virus CoV-2, detecție virus influenta A, detecție virus influenta B, detecție virus sincițial respirator (RSV). Cele două linii complet automatizate RT-PCR integrează etapele de extracție, preparare master mix, amplificare și interpretare software, reducând variabilitatea operator-dependentă și riscul de contaminare încrucișată. Sensibilitatea analitică și limita de detecție sunt optimizate pentru aplicații clinice, inclusiv detecția agenților patogeni și a mutațiilor somatice sau germinale.
În cadrul asistenţei medicale moderne, laboratorul clinic se defineşte ca un motor-instrument centric, cu volum şi randament crescut, care asigură direcționarea rapidă și precisă a probelor, eficientizând fluxul de lucru.
Având în vedere rapiditatea evoluției tehnologiei în domeniul medical, o preocupare majoră rămâne dotarea cu echipamente „state of art” în domeniul paraclinic, îmbunătățirea permanentă a activității specifice de laborator, instruirea personalului pentru a putea răspunde cerințelor de calitate și competență, precum și mentoratul tinerelor generații de specialiști în domeniu.
– Cum a schimbat Covid-ul munca laboratorului?
– În contextul pandemiei de COVID-19, laboratorul a devenit unitatea centrală, necesitând o reorganizare riguroasă și o adaptare, trecând de la rutina zilnică la o creștere a capacității de testare moleculară (RT-PCR). Schimbările au intervenit atât la volumul de muncă, cât și în ceea ce privește efectuarea unor proceduri și protocoale de analiză, de biosiguranță și logistică.
Diagnosticul molecular reprezintă un domeniu în dezvoltare rapidă a medicinei de laborator prin investigarea genomurilor umane, virale şi bacteriene precum şi a produselor pe care acizii nucleici le codifică. Astfel, în timpul pandemiei COVID-19 s-au efectuat peste 120.000 de teste prin tehnica RT-PCR.
Laboratorul de Genetică și Biologie Moleculară funcționează în continuare ca o platformă integrată de diagnostic molecular, genomic și citogenetic, structurată conform principiilor de workflow unidirecțional și control riguros al contaminării, în concordanță cu standardele internaționale de calitate pentru laboratoare de genetică și biologie moleculară.
Pandemia a adus un plus valoare laboratorului pe termen lung, atât prin dotările performante care au dus la rezultate mai rapide și mai acurate, capacitatea personalului de a face față evenimentelor stresante și a le depăși cu succes, cât și prin digitalizare asigurând conectarea în timp real cu toate structurile implicate.
– Ce lucruri mai deosebite se pot face aici spre deosebire de alte laboratoare din oraș? Ce au găsit deosebit în timp?
– În cadrul laboratorului Clinic de Analize Medicale, pe lângă analizele de rutină, se efectuează analize moderne în concordanţă cu sistemele de sănătate europene pentru diagnostic de certitudine şi terapie ţintită în patologiile cu impact în populaţie (ex.: cancer, diabet zaharat, SIDA, infecţii virale, infecţii spitaliceşti şi comunitare).
Există, de asemenea, capacitatea de determinare a substanțelor toxice în sânge, urină, screening toxicologic pentru medicamente, droguri și substanțe psihoactive, analize pentru intoxicații acute și cronice, monitorizarea expunerii profesionale la substanțe chimice, control toxicologic ocupațional, analiza metalelor grele, identificarea alcoolului și a metaboliților acestuia, determinarea concentrațiilor plasmatice ale medicamentelor și ale metaboliților acestora.
Având în vedere că SCJUPBT are două secţii de Obstetrică Ginecologie, maternitatea fiind de gradul III cu adresabilitate atât pentru oraşul Timişoara, cât şi întreg judeţul Timiş şi judeţele limitrofe (Arad, Caraş-Severin, Hunedoara), dotarea modernă, ne permite să dezvoltăm un sistem regional de screening prenatal genetic, ceea ce contribuie la reducerea drastică a costurilor sistemului de sănătate.
Integrarea tehnologiilor de extracție automatizată, amplificare și detecție moleculară, secvențiere de înaltă performanță și analiză citogenetică permite laboratorului să furnizeze diagnostice genetice comprehensive, cu sensibilitate, specificitate și acuratețe analitică ridicate. Prin implementarea procedurilor standardizate, controlului intern și extern al calității și a fluxurilor optimizate, laboratorul susține medicina genomică și abordarea personalizată a pacientului, la nivel de excelență profesională.
– Au fost perioade de probleme cu reactivii?
– Având în vedere importanța diagnosticului de laborator în managementul cazurilor clinice, precum și sistemul de calitate implementat cu succes, este imperios necesar a se acorda o importanță deosebită aprovizionării cu reactivi și consumabile de laborator. De-a lungul timpului managementul de vârf a înțeles acest deziderat și a asigurat sprijin în ceea ce privește activitatea laboratorului, răspunzând întotdeauna pozitiv solicitărilor medicilor și pacienților care se adresează unității noastre în vederea asigurării unui diagnostic precoce și unui management optim de caz.
– Cît de căutată e munca de laborator la noile generații de medici rezidenți și asistenți?
– Există o nevoie constantă de medici de laborator, în prezent ocupându-se toate locurile scoase la concursul de rezidențiat, ceea ce denotă că este o specialitate căutată deoarece implică utilizarea unor tehnologii noi, inclusiv cu potențial în cercetare. Automatizarea și tehnologiile de înaltă performanță ajută medicii de laborator, nu îi exclud, rolul lor de diagnosticieni fiind unul proactiv.
Medicina de laborator rămâne o opțiune de carieră promițătoare, cu o cerere ridicată și o importanță semnificativă în domeniul medical.
– Există un fel de frustrare a lipsei de contact cu pacientul, care probabil că deseori nu realizează cât de importantă e munca laboratorului sau, dimpotrivă, asta ușurează lucrurile, protejând oamenii ce lucrează aici?
-Medicii de laborator au un rol crucial în diagnosticarea corectă și rapidă a pacienților, în stabilirea prognosticului bolii și monitorizarea răspunsului terapeutic.
De asemenea, sunt implicați constant în activitatea de consiliere atât direct, a pacienților, cât și a medicilor clinicieni în ceea ce privește alegerea celor mai specifice și performante metode de diagnostic. Totodată, medicii de laborator sunt responsabili cu asigurarea calității analizelor, menținerea standardelor de calitate implementate, imbunătățirea continuă și creșterea permanentă a încrederii medicilor clinicieni și a pacienților.
– Cum e colaborarea cu zonele care ard – de exemplu Urgențele?
– Laboratorul Clinic de Analize Medicale are un compartiment dedicat pentru analizele de urgență, în care activitatea se desfășoară 24 de ore din 24. Compartimentul este dotat cu analizoare performante, cu viteză mare de lucru, astfel încât diagnosticul și deciziile terapeutice să fie stabilite cu promptitudine. Compartimentul Analize de urgență deservește atât pacienții care se adresează în Unitatea de Primiri Urgențe (UPU), cât și pacienții internați în secțiile spitalului, a căror stare de sănătate devine o urgență. Există o comunicare permanentă cu medicii trimițători, rezultatele critice fiind comunicate de urgență.
– Este pregătit laboratorul pentru cazul reînceperii transplantului renal?
– Pot spune că laboratorul spitalului nostru deține atât infrastructură, cât și personal calificat pentru efectuarea testelor necesare. Desigur, împreună cu specialiștii clinicieni, trebuie stabilit un protocol clar de lucru conform legislației în vigoare, deoarece transplantul renal implică mult mai multe, nu doar testele de laborator în sine, ci și multiple condiții medicale, psihologice, și nu în ultimul rând administrative, foarte riguroase pentru a asigura o reușită.
– Există lucruri ce vin în viața de toate zilele în paralel cu munca de laborator? De exemplu o anume pedanterie, sau un pattern în aranjarea lucrurilor, sau eventuala germofobie?
– Este adevărat că activitatea de laborator se potrivește persoanelor pedante în sensul de persoane organizate, minuțioase, atente la detalii, cărora le plac ordinea și curățenia.
– Avem personal implicat în activitatea UMFT. Cum se lucrează cu studenții și cu rezidenții?
– În cadrul Laboratorului Clinic Central de Analize Medicale îşi desfăşoară activitatea un personal calificat şi devotat meseriei pe care o practică: medici de specialitate, asistenţi, biologi, chimişti, registratori medicali, cadre didactice ale UMF “Victor Babeş” Timişoara cu activitate integrată şi personal auxiliar. Universitatea de Medicină şi Farmacie “Victor Babeş” Timişoara a sprijinit acest laborator şi din punct de vedere al dotării cu aparatură performantă, cu atât mai mult cu cât aici îşi desfăşoară pregătirea studenţi, rezidenţi în specialitatea laborator clinic, microbiologie clinică sau farmacologie clinică, precum şi masteranzi şi doctoranzi.
Iar la a doua parte a întrebării aș spune că „Omul sfințește locul”.
– Există un portret robot al candidatului potrivit pentru munca de laborator?
– Nu există un portret robot al personalului de la laborator, există doar dorință de a ajuta, de a fi alături de semenii noștri și evident meticulozitatea, spiritul de echipă, empatia, rezistență la stres și capacitatea de adaptare la situații inopinate, toate aceste calități definesc în mare măsură meseria aceasta.
– Cum ai ajuns la munca asta – care a fost rolul întâmplării?
– Am încredere că nimic nu este întâmplător, și că până la urmă fiecare își găsește locul potrivit. Important este să facem cu pasiune și dedicare tot ceea ce facem, să fim conștienți că suntem în slujba pacienților.
– Există părți foarte plăcute și părți mai puțin plăcute din meserie despre care ai putea vorbi?
– Nu aș putea spune că există părți neplăcute din moment ce îți alegi cu bună știință această specialitate, dar poate te referi aici la multiplele matrici biologice care, pe lângă sânge/plasmă implică: urină, materii fecale, lichide biologice multiple (lichid cefalorahidian, lichide de puncție, lichid de spălătură), salivă, sudoare sau alte tipuri de secreții. De asemenea, putem vorbi despre fragmente de țesuturi, păr sau unghii în cazul analizelor toxicologice. Dar, cum poate părea mai puțin plăcut, tot așa poate deveni foarte provocator și în același timp satisfacția este pe măsura provocării.
Un exemplu de parte plăcută ar putea fi aflarea unui diagnostic „din întâmplare”, fără ca pacientul să fi fost cunoscut cu o anumită boală, și atunci satisfacția este din nou pe măsură. Deci, oricât de greu sau mai puțin plăcut poate părea un lucru, acesta vine totuși cu satisfacții. Și aceasta este și filosofia după care îmi ghidez studenții și chiar propriul copil și anume că „efortul este întotdeauna răsplătit”. De asemenea, este foarte plăcut să lucrezi în echipă, este plăcut să ai parte de aparatură inovatoare și variată, posibilitatea să participi la cercetări împreună cu colegii din toate specialitățile, până la urmă munca de laborator se pliază pe orice, ajută la prevenție, diagnostic, tratament, inovare, într-un cuvânt este foarte greu să te plictisești în laborator.
– Din ce muncă de cercetare ai făcut parte, ca medic de laborator, până acum?
– Echipa laboratorului se implică activ şi în domeniul cercetării medicale, care se face printr-o strânsă colaborare cu secţiile clinice universitare din cadrul spitalului, drept urmare, laboratorul este implicat şi în derularea a numeroase studii clinice. Atât datorită personalului calificat cât şi a aparaturii performante s-au putut atinge toate standardele de calitate care au dus la recunoaşterea performanţelor acestui laborator.
Această strânsă colaborare între laborator și secțiile spitalului a avut ca rezultat în ultimii ani atragerea de fonduri prin proiecte europene şi transfrontaliere prin care s-a reuşit dotarea laboratorului cu aparatură modernă de înaltă performanţă.
În vederea modernizării şi funcţionării la cel mai înalt nivel al compartimentului de Biologie Moleculară, pentru a putea ţine pasul cu noile descoperiri şi cercetarea în domeniu, precum şi dezvoltarea profesională continuă, conducerea laboratorului a depus în 2019 şi a câștigat un proiect finanţat din fonduri europene („Improvement of the neoplazic pathology management through the development and implementation of cross border medical excellence center„ NEO-PAT-MAN) prin care spitalul şi implicit pacienţii beneficiază de un secvenţiator şi echipamente conexe pentru detectarea şi cuantificarea agenţilor patogeni, a biomarkerilor de diagnostic şi orientare terapeutică, în special pentru patologia neoplazică, precum şi predispoziţia genetică la anumite patologii. Totodată, proiectul a înlesnit accesul specialiştilor la tehnica de ultimă generaţie, prin cursuri şi workshop-uri organizate gratuit în cadrul proiectului pentru studenţi, rezidenţi, tineri cercetători, biologi, chimişti, biochimişti.
Între anii 2022 – 2024 împreună cu Spitalul Clinic Municipal de Urgență din Timișoara am participat la un proiect intitulat „Dezvoltarea unui sistem regional de centre medicale de excelență în screening prenatal în regiunea de vest”.
În anul 2023, a fost câștigat Proiectul transfrontalier RO-HU, intitulat ”Microbial infection and colonization in pregnant women and newborns”.
Împreună cu colegii de la Nefrologie, Diabet și Endocrinologie, sub egida UMFVBT am participat în două proiecte de succes și anume: „Diagnosis relevance of urinary podocytes as markers of the cytoprevention concept”, și „Translational innovative study from basic research to clinical applicability with regard to mitochondrial dysfunction and inflammation in diabetic kidney disease” care de-a lungul timpului s-au soldat cu publicații științifice valoroase.
În laborator se desfășoară și multiple cercetări doctorale în urma cărora colectivele implicate au publicat și publică în continuare articole valoroase și participă la diseminarea datelor la manifestări științifice naționale și internaționale.
– Ți-am povestit cândva despre profesorul meu de biologie din liceu, care ne-a conectat pe mulți la „logica viului” și a avut contribuția lui la faptul că mulți dintre colegii mei au ajuns medici. Ai cumva în spate o astfel de persoană, care te-a capacitat spre munca aceasta?
– Cred că fiecare dintre noi are un moment în care ceva ce nu era vreodată luat în considerare devine realitate, și, de cele mai multe ori acest lucru devine posibil pentru că într-un moment din viață întâlnești un om care îți schimbă total percepția. În cazul meu este vorba despre dl. Profesor dr. Victor Dumitrașcu care cumva a crezut în mine și mi-a deschis apetitul spre studiu, mi-a deschis orizontul asupra importanței diagnosticului de laborator în acest „puzzle”, acest întreg care este ființa umană, pacientul. Abordarea dumnealui, atât din punct de vedere științific, cât și uman, de a vedea pacientul ca un întreg, a fost pentru mine momentul în care am ales această specialitate, am realizat importanța unui diagnostic paraclinic.
– Bei apă de la robinet? Mănânci ciudățenii atunci când te afli în țări cu mâncare stradală… să spunem diferită de a noastră?
– Nu mai beau de mult apă de la robinet, din copilărie, și parcă mi-e și dor de perioadele când mergeam fără frică la robinet și beam acea apă chiar dacă mirosea a clor și nu am pățit nimic. Nu mănânc ciudățenii, deoarece sunt destul de pretențioasă în ceea ce privește alimentația, am rămas destul de clasică, îmi place gustul copilăriei și manânc cu plăcere mâncarea cu care am crescut.
*
Spuneam, la începutul materialului, de împărțitul grădinii. Și nu mă refeream la pusul parafei pe rezultatele obținute aici, în laborator, deși, sigur, și aceea e o împărțire. Ci la faptul că, mereu, și după noi trebuie să vină cineva, și tot o creștere e, și o împărțire, în timp ce noi descreștem întrucâtva din puteri.
Pentru că dr. Daliborca Vlad e, cum am spus de la început, și profesor, la Universitatea de Medicină și Farmacie „Victor Babeș”, din Timișoara. Și dacă își folosește măcar jumătate din puterea de convingere pe care mi-a arătat-o mie atunci când mi-a prezentat ce face laboratorul ei măiastru, atunci știu că generațiile următoare sunt pe mâini bune, și că, dintre studenții de azi, vom avea oameni care vor alege medicina de laborator drept harul luptei lor în alb.
În timp ce ne luăm rămas bun, în fața Județeanului, mă mai opresc o clipă să-i pozez mărțișorul îndemn ce îi atârnă pe piept, cum încă suntem în luna fragilelor cadouașe ce se agață în șnur roșu cu alb. Dar aici nu este vorba despre fragilitate, neapărat, ci despre putere – a minții, a priceperii, a grației feminine. Ideea de demult, cu „femeia care trebuie să stea în bucătărie” e schimbată după timpul din care facem amândouă parte și căruia îi arătăm ce putem: „femeia e de stat în laborator”. Așa e, stăm peste tot unde e făcut ceva interesant. Și nu doar stăm, sau aparținem de locul respectiv, ci schimbăm și contăm. Go, girl!
Ramona Băluțescu